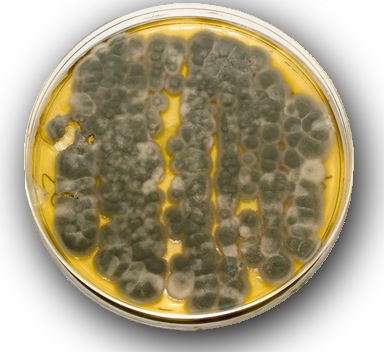

This week a colleage of mine shared an interesting video describing AI (mainly Suno) as problematic to the musical industry in the sense that musicians will become less and less skilled in making truly original music. It coins the term “de-skilling”, which perfectly captures something I also see in the software development area, even though it is beautifully hidden by the “impressive results”.
This week a colleage of mine shared an interesting video describing AI (mainly Suno) as problematic to the musical industry in the sense that musicians will become less and less skilled in making truly original music. It coins the term “de-skilling”, which perfectly captures something I also see in the software development area, even though it is beautifully hidden by the “impressive results”.
Tag: environment
Reading an ISKRA AM550 P1 Port with a Pi
 Although I am the guy with a soldering iron and a bit of software development experience, I am not a fan of the “internet of things”, “smart meters” or smart anything really. Not because I don’t like technology, but because of the potential security and privacy problems it brings with it. That said, because of some unfortunate events I now have a smart meter my home. So when life gives you lemons, you make Pi!
Although I am the guy with a soldering iron and a bit of software development experience, I am not a fan of the “internet of things”, “smart meters” or smart anything really. Not because I don’t like technology, but because of the potential security and privacy problems it brings with it. That said, because of some unfortunate events I now have a smart meter my home. So when life gives you lemons, you make Pi!
I’ve got an AM550 Smart meter with a P1 port. Seeing all the online content and suggestions about reading your smart meter, I decided to have an hour of fun trying to read the P1 data. Here’s how I did it:
The Pan Rant
 You may have seen recent tweets from me ranting about my frying pans. I’ve ruined a few (very expensive) pans and replaced them with dirt-cheap pans which are actually much better. I would like to share my experiences and solutions with you, so that you can buy the right (cheap) pan without having to go through the same thing. Links to all the pans are in the article below.
You may have seen recent tweets from me ranting about my frying pans. I’ve ruined a few (very expensive) pans and replaced them with dirt-cheap pans which are actually much better. I would like to share my experiences and solutions with you, so that you can buy the right (cheap) pan without having to go through the same thing. Links to all the pans are in the article below.
Catnip Watering System
Here’s a one minute how-to on growing catnip without having to water your plants every day.
[youtube=http://www.youtube.com/watch?v=6jyqNzNeQeE]
Problem Solving for Dummies
Some people can not seperate cause and effect when solving problems, and every now and then you run into a great example.
| If this is your problem… | this is not your solution |
 |
 |
The towel bin is next to the sink. Why would anyone walk all the way back to the toilet to throw their paper towel in there? Well maybe it’s because they have nowhere to put it? There is a simple solution to solving problems with other people’s behavior, without having to put up signs and making up silly rules:
Make the right thing to do
the easy thing to do.
spacing
Why Growth is a bad thing. Bad.
Quite often I am amazed at people’s ability to miss what looks obvious to me. Not only the small things like cleaning up when you spill coffee over the floor, or washing your hands when you get off the toilet, but also bigger things. Like the silly “solutions” to the world’s pollution problem for example.
Quite often I am amazed at people’s ability to miss what looks obvious to me. Not only the small things like cleaning up when you spill coffee over the floor, or washing your hands when you get off the toilet, but also bigger things. Like the silly “solutions” to the world’s pollution problem for example.
Looking to solve our pollution problem by changing people’s behavior is one of the things which to me is obvious to fail. Although some behavior may speed up pollution, in the end we all pollute, wether we like it or not.
At the risk of writing a very unpopular blogpost, I’d like to share some thoughts on the ongoing and ever increasing pollution problem. In my eyes, there are 2 real causes of pollution, and ultimately these causes are even self-repairing although you may not like how that works out for you.
Give me spots on my Apples
 Lately Greenpeace has started a campaign against the usage of hazardous materials by Apple. The campain setup is friendly, nicely designed and urges Apple to choose materials which are less hazadous to the environment.As a spinoff of the Greenpeace campain all kinds of so called “journalists” have begun to put Apple on the “wrong end of the scale” of their “environment-o-meter”, and are happily writing doom articles about what will happen to your Karma if you buy any Apple product. But how environmentally unfriedly are Apple’s computers really?
Lately Greenpeace has started a campaign against the usage of hazardous materials by Apple. The campain setup is friendly, nicely designed and urges Apple to choose materials which are less hazadous to the environment.As a spinoff of the Greenpeace campain all kinds of so called “journalists” have begun to put Apple on the “wrong end of the scale” of their “environment-o-meter”, and are happily writing doom articles about what will happen to your Karma if you buy any Apple product. But how environmentally unfriedly are Apple’s computers really?
Soybean racer
Now that a few school kids have proven that you don’t need oil to race, and several American race series run on methanol (no that’s not an oil product), can we please stop making cars that run on gasoline? And by the way, also stop pumping money into the super-dangerous liquid nitrogen cars? All that is purely to keep the oil companies in the same place: monopoly. Do you really think they do it for the environment? What if I told you that your current petrol car can run on bio-degradable methanol, with almost no changes? If you have a very modern car, the fuel system will even auto-adapt! But noooo, they won’t tell you that, because the oil companies and governements want to keep the monopoly intact!
Not that you can really do anything about it though. Except maybe not buying liquid-nitrogen or hybrid cars. There are better technical alternatives, although not on the market yet. Boycot the “environmentally friendly” car, force them into making a *real* environmentally friendly car.
Yes, I’m driving a diesel, and a motorbike. And no, I’m not worried about oil-shortage. It’s all bullshit from the oil companies, who could have come up with alternatives a long while ago, but chose not to. If there really was an oil shortage, we all would have been driving on methanol for quite some time now. And co2 emmisions would have been reduced to absolutely 0.